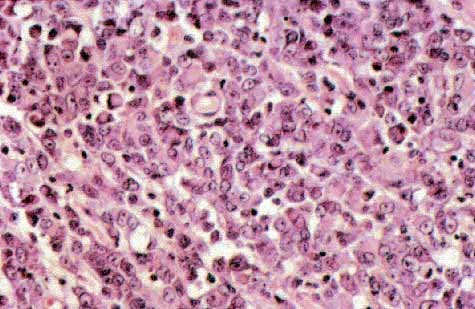
fig. 4

Comunicación
Nş 066
Comunicación |
Alvarez-Argüelles, H; García Castro, C; García Montelongo, R; Manzano Sanz, C; Herreros, V; Guerra, A; Diaz-Flores, L.
 |
| Fig 1: Aspecto macroscópico de la lesión de la espalda de la paciente. |
 |
| Fig 2: Dos crecimientos tumorales cutáneos enfrentados. La lesión más hipercelular corresponde al crecimiento sarcomatoso rabdoide ( H-E x 40). |
 |
| Fig 3: Tumor rabdoide maligno de la piel. Se observa el dermis masivamente infiltrado por células tumorales (H-E x 200). |
|
| Fig 4: Con mayor aproximación se aprecian células rabdoides, algunas con características inclusiones hialinas paranucleares (H-E x 400). |
 |
| Fig 5: Tumor miofibromatoso. En Dermis se observa proliferación fusocelular arremolinada con fibras de colágena, junto a estructuras vasculares ectásicas (H-E x100). |